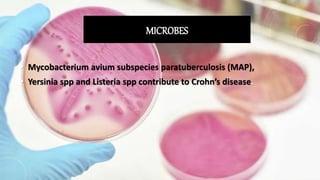
MICROBES
• Mycobacterium avium subspecies paratuberculosis (MAP),
• Yersinia spp and Listeria spp contribute to Crohn’s disease.

1. Crohn's disease is a chronic inflammatory bowel disease that causes inflammation of the digestive tract and can affect any area from mouth to anus. It is characterized by abdominal pain, diarrhea, and weight loss.
2. The causes of Crohn's disease are unclear but involve genetic susceptibility and an abnormal immune response to environmental triggers like bacteria or viruses. There is no cure for Crohn's disease but treatment aims to induce and maintain remission.
3. A qualitative study interviewed 30 Crohn's disease patients and identified 13 themes of how the disease impacts their quality of life such as nutrition, hygiene, relationships, and autonomy. The study provides insights beyond just symptoms to understand the full effects of living with

![MEDICAL MANAGEMENT:
• ANTI- INFLAMATORY DRUGS:
• anti-inflammatory drugs are the first step in the treatment of Cronh’s
disease and are appropriate for the majority of people with this
condition. These drugs include:
• 5-aminosalicylates [sulfazine which help to control moderate
symptoms]
• Corticosteroids [prednisone, hydrocortisone, methylprednisolone and
budesonide]](https://image.slidesharecdn.com/crohnsdiseasepresentation-210603182627/85/Crohns-disease-presentation-42-320.jpg)



















